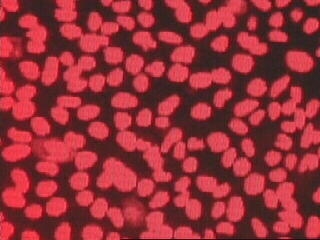
Stem Cells and Snowflake Kids

Stem Cells and Snowflake Kids
It's the scientific issue dividing America and the one bill President Bush has used his veto on. Should embryos left over from IVF be used for embryonic stem cell research?
It's the scientific issue dividing America and the one bill President Bush has used his veto on. Should embryos left over from IVF be used for embryonic stem cell research?
Steve Johnson plays with his four-year-old daughter, Zara. He's a paraplegic and his only hope of walking is a medical breakthrough, promised from embryonic stem cell research. But Zara is a 'snowflake child', born from a donated embryo which might have been used in this research. "Is it okay for me to benefit if it means killing what could become someone else's child?" he ponders. There are an estimated 400,000 embryos left over from IVF programmes. In recent years, the debate on whether they should be used for embryonic stem cell research has grown increasingly heated. Pictures of President Bush, surrounded by a group of 'snowflake children' were beamed around the world. He justified vetoing a bill to increase state funding for this research on the basis that; "Children are not spare parts." But talk like this dismays many scientists. "Stem cell research should not be a political or religious issue", states Dr Gabriela Cezar. Governor Jim Doyle agrees; "I cannot believe we would shut down the research that might find the cure for illnesses like Parkinson's".
FULL SYNOPSIS

